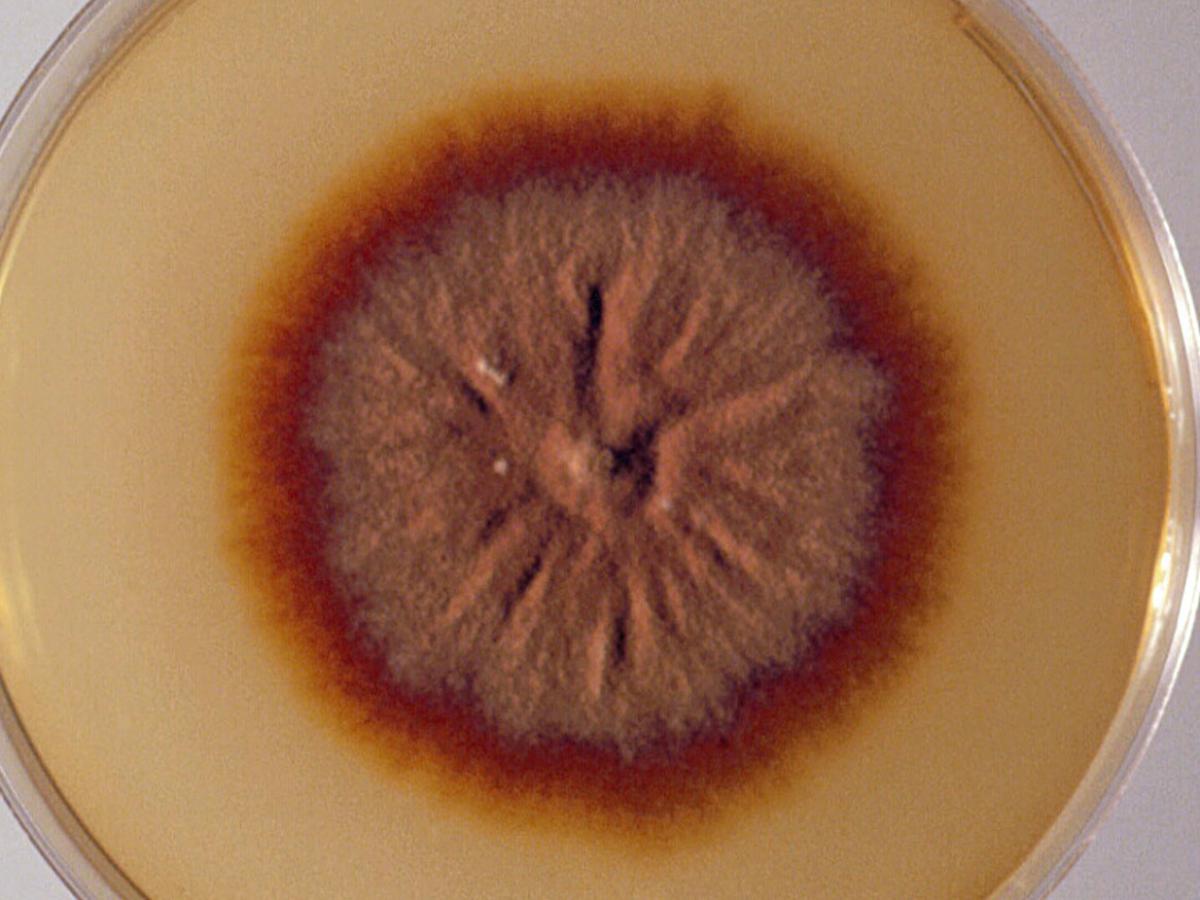
Culture

Status message
Correct! Excellent, you have really done well. Please find additional information below.
Unknown 27 = Trichophyton tonsurans
Clinical presentation: T. tonsurans infection of a nail (tinea unguium).

Direct microscopy: Hyphal elements of T. tonsurans ramifying through skin scales mounted in 10% KOH and Parker ink solution.

Culture: Cultures of T. tonsurans show considerable variation in texture and colour. They may be suede-like to powdery, flat with a raised centre or folded, often with radial grooves. The colour may vary from pale-buff to yellow, which may resemble Epidermophyton floccosum, to dark-brown. The reverse colour varies from yellow-brown to reddish-brown to deep mahogany.
Microscopy: The hyphae are relatively broad, irregular and much branched with numerous septa. Numerous characteristic microconidia varying in size and shape from long-clavate to broad-pyriform are borne at right angles to the hyphae, which often remain unstained by lactophenol cotton blue.

Very occasional smooth, thin-walled, irregular, clavate macroconidia may be present in some cultures. Numerous swollen giant forms of microconidia and chlamydoconidia are produced in older cultures.

Key Features: Microscopic morphology culture characteristics, endothrix invasion of hairs and partial thiamine requirements.
Comment: Trichophyton tonsurans is an anthropophilic fungus causing inflammatory or chronic non-inflammatory finely scaling lesions of skin, nails and scalp. A common cause of tinea capitis in the Indigenous Australian and in the African-American populations. Invaded hairs show an endothrix infection and do not fluoresce under Wood's ultra-violet light.
About Trichophyton Back to virtual assessment